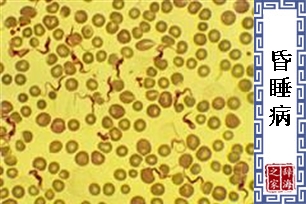
昏睡病

【昏睡病】 基本信息(拼音,读音等)
 我要纠错
我要纠错
【昏睡病】是什么意思
- 病名。因患者有昏睡症状,故称为「昏睡病」。分为二类:一、因脑部发炎,导致心智、体力、能力降低而昏睡的疾病。二、由锥虫感染而发病,媒介为嗤嗤蝇(Testse Fly) 。患者有发烧、头痛、痉挛等症状,末期甚至呈昏睡状态而死亡。多发生在非洲中西部一带。
【昏睡病】 图片鉴赏
查字典的部份资料来自网络或由网友提供,不保留版权,如有侵权,请与我们联系以从站上删除! 免责声明:本站非营利性站点,以方便网友为主,仅供学习。
Tip:SCCG